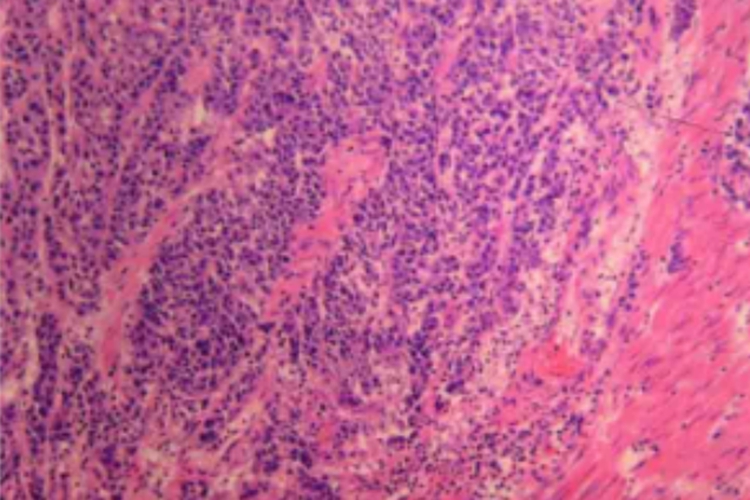
低分化管状腺癌组织病理图

概述
胃癌是指源于胃黏膜上皮细胞的恶性肿瘤,多数是腺癌。
胃癌病理报告单可呈现病灶对黏膜侵袭程度等情况。
病理表现
从大体观上分析,早期胃癌是指病灶局限且深度不超过黏膜下层的胃癌,不论有无局部淋巴结转移;病理呈高级别上皮内瘤变或腺癌。进展期胃癌深度超过黏膜下层,已侵入肌层者称中期;侵及浆膜或浆膜外者称晚期胃癌。

从胃癌的组织病理学分析,可将胃癌分为腺癌(管状腺癌、黏液腺癌、混合型腺癌、肝样腺癌)、腺鳞癌、髓样癌、印戒细胞癌、鳞状细胞癌和未分化癌等。根据癌细胞分化程度可分为高、中、低分化三大类。
高分化管状腺癌具有规则的腺体结构,可见基底膜,常与化生的肠上皮极为相似,癌细胞高柱状或立方状,核深染,有异型性,部分细胞核上移。中分化管状腺癌的管状结构不如高分化型规则,大小差异明显,排列紊乱,相邻的腺管可相互融合,基底膜不明显,细胞脱离腺管基底,相互挤压,核深染。低分化管状腺癌的腺体难以辨认或高度不规则,或单个细胞孤立排列,或多个细胞呈大小不等实性条索状,其中可见黏液分泌或形成腺泡结构。

侵袭与转移
胃癌的好发部位依次为胃窦、贲门、胃体,胃癌有四种扩散方式,具体如下:
直接蔓延
侵袭至相邻器官,胃底门癌常侵犯食管、肝及大网膜,胃体癌则多侵犯大网膜、肝及胰腺。
淋巴结转移
一般先转移到局部淋巴结,再到远处淋巴结。
血行播散
最常转移到肝脏,其次是肺、腹膜、肾上腺,也可转移到肾、脑、骨髓等。
种植转移
癌细胞侵及浆膜层脱落入腹腔,种植于肠壁和盆腔,也可在直肠周围形成结节状肿块。
参考文献
[1]葛均波,徐永健,王辰.内科学.第9版[M].北京.人民卫生出版社.2018.364-366.
[2]王天宝,尉秀清,崔言刚,任军主编.实用胃肠恶性肿瘤诊疗学上普及版[M].广州.广东科技出版社.2018.134-136.
展开






